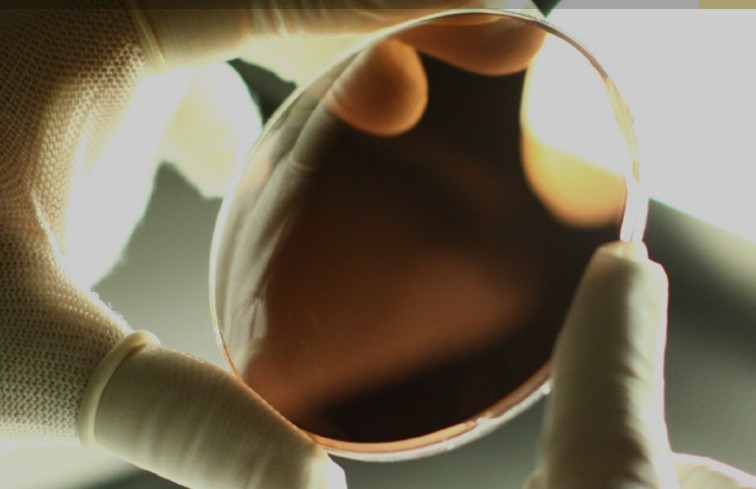
タレックス偏光レンズ

タレックス度付きサングラス 偏光レンズ
乱反射、ギラツキをカットする、目に優しい快適なレンズです。レンズの中に偏光フィルムを入れることで反射光を抑えます。

TALEXレンズの概要 タレックス偏光レンズをもっと知ろう
目次
偏光レンズ仕様は各社さまざまな製法で制作していますが、唯一無二の見え方を感じることができる偏光レンズです。
世界唯一の偏光レンズメーカーTALEX。正真正銘のMade in JAPAN、製造工程の60%がハンドメイド。
オリンピックの指定サングラスやプロスポーツ選手の愛用品に選ばれるなど呼び声は高く、世界唯一のメーカーと言われています。

TALEXの偏光技術
世界で唯一の雑光®カットフィルター。この繊細さはハンドメイドでしか表現できません。
目に有害な”雑光®”と紫外線をしっかりカットし、優れた解像力を手に入れるには、長年積み重ねられた繊細な技術と経験が必要です。雑光®カットフィルターの製造から最終仕上げまで、自社工場で一貫生産しているからこそ実現した高性能フィルターです。

他社には真似ができないTALEX技術の中核―それは
独自に開発した「雑光®カットフィルター」をレンズに直接はめ込むことです。
量産されている安価な偏光フィルターは扱いやすいように加工されていますが、タレックスが扱う薄さ驚異の0.03mmという驚くほどデリケートな「雑光®カットフィルター」をレンズに合わせるには、想像を絶する高度な技術が要求されます。
「ひずみ」「揺れ」「赤ぬけ」などを起こさないタレックスの偏光レンズ。
目に優しい光だけを通す独自の技術は、長い年月の間に培われた職人たちの“技”によって生み出されています。

TALEX偏光レンズは独自の『雑光®カットフィルター』を仕様することで、「光を遮断する」のではなく、「目に有害な光だけを取り除く」ということで快適な視界をえることができるのです。
例えば、「光の空気清浄機」のように空気中のチリやホコリ・花粉などを取り除くのと同じように、光にも紫外線や太陽・照明の照り返しなど、直接目に触れることでストレスホルモンを上昇させる有害な雑光®を取り除くことができるのです。
白内障をはじめとする水晶体疾患が猛威を振るう現代、有害な光から瞳を守るためにもっとも手軽で確実な方法として『雑光®カットフィルター』の存在は様々な分野で注目を集めています。
偏光性能について

偏光度(雑光カット率)の高さ
一般的に偏光レンズの濃度が薄いと、偏光度の効果を発揮することが難しくなります。
しかしTALEXレンズは、独自の「雑光カットフィルター」にヨード系原料を用いることで、高い雑光カット率を実現しました。他の偏光レンズレンズと比べれば歴然に違いが判ります。

世界トップクラスの偏光フィルター接着技術
偏光レンズの間に入っている偏光フィルターの密着性能は、偏光を効果を発揮する大切な要素です。
TALEXでは1938年の創業以来の技術蓄積と、全行程の60%以上をハンドメイドで製作することで、世界に誇れる技術を維持しています。

赤ヌケ現象の発生を防ぐ
ポリカーボネイト製偏光レンズの場合、可視光線(赤色)を透過してしまいます。
水面に赤いチラつきが出たり消えたりし、眼性疲労やストレスの原因となります。
TALEXでは、ヨード染色をしているため、可視光線(赤色)を99%以上カット。赤ヌケは全く発生しません。
偏光レンズTALEXの種類
『タレックスレンズ』のカラーバリエーションにはすべて意味があり、四季の美しい日本で、あなたが過ごしたいライフスタイルに適した偏光レンズカラーを大別しています。



NATURAL シリーズ
雑光®を抑えながら、色彩や繊細な光学要素を損わないという特徴があり、あらゆる状況や場面などで活躍します。
CONTRAST シリーズ
立体的で鮮明な視界を提供するとともに、長時間使用でも疲れにくいという特徴があり、アクティブなシーンはもちろん、日常生活でも快適な視生活を送ることができます。
MO’EYE シリーズ
パソコンやスマートホン、iPadの蛍光灯による眩しさをやわらげるという特徴があり、室内作業時の目の負担を軽減し、集中力を高めてることができます。
BRIGHT シリーズ
眩しさを抑えながら、明るく鮮明な視界を叶えるという特徴があり、視界が暗くなることに敏感な方には特におすすめの偏光レンズです。

NATURAL
自然のままの色に見えます。
トゥルービュー®
晴れ、曇り、雪さまざまな天候でも人が快適と感じるように、雑光カット率と可視光線透過率の最適なバランスを追求して制作。さらに、目に飛び込む色彩をありのままに再現します。“雑光”を抑えながら、景色の色彩やディテールを損わないトゥルービューは、あらゆるシチュエーションやジャンルでリアリティ溢れる視界を提供します。

●余分な眩しさだけを取り除く

●目にする景色をありのままに
トゥルービュー スポーツ
ナチュラルな視界に、対象物の速い動きや変化をクッキリと見逃さないコントラスト性能をプラスして制作。すべてのスポーツシーンに対応するオールマイティなレンズカラーです。

●ナチュラルな視界に

●コントラスト性能を付加
トゥルービュー フォーカス
厳しい照り返しや眩しさを、ナチュラルな色合いで目元を優しくソフトに感じさせクールダウンさせます。海上や雪山などの強い光が視界を妨げる環境を目に優しいシーンへとシフトします。

●厳しい照り返しをカット

●眩しさを驚くほどカット
ピース グレー
屋内や屋外における“雑光”を適度にやわらげながら、ナチュラルな色合いで光を整えるリラクゼーションカラーです。色誤差を抑えた視界は、街並みを落ち着いたシーンへとシフトします。

●ナチュラルな色合いで快適

●“雑光”をカットしてスッキリ
トゥルービュー ゴルフ
ナチュラルな視界に距離感を感じることができる適度なコントラスト性能をプラス。芝の反射を抑えることでボールの行方はもちろん、障害物の位置を明確にし、迷いなくプレーに集中できます。

●ナチュラルな視界に

●距離感を読む洞察力
AIRY GREEN
あらゆる方向からの強い光を森の中にいるようなマイルドなシーンへとシフト。強いと感じる眩しさをしっかり抑え、視認性と集中力をサポートします。

●強い光をマイルドな光へ

●落ち着きのある見え方に
CONTRAST
シャープで立体的に見えます。
アクション コパー
物体を見た時の目への優しさをキープしながらも、高コントラストで奥行きのある視界を実現。様々な動きや変化を捉えるシャープな視界が特徴です。

●眩しさを最大限抑える

●対象物を立体的に
ラスター ブラウン
さまざまな天候に対応し、風景の臨場感を損なうことなく眩しさをカット。コントラストがあり日陰でも暗さを感じさせない、高感度で温かい視界が特徴です。

●景色の臨場感を感じます。

●自然な光を損なわなく見える。
ピース ブラウン
屋内、屋外の“雑光”を適度にやわらげながら、暖かい色合いで光を整えるためスッキリとした輪郭で物体を見ることができます。街並みをソフトで落ち着いたシーンへとシフトします。

●温かくソフトな視界を体験。

●色合いで“雑光”を整える。
アーシー ブラウン
雪面やビーチなど白い場所に降り注ぐ強い光や水面の光などの反射を抑え、集中力や判断力をサポート。白く強い光を優しい光へと変え、目への負担を軽減します。

●強い光をソフトな光へ。

●温かみのある光に感じます。
エアリー パープル
太陽光の直接的な眩しさを抑え、臨場感を際立たせる視界。白を基調とする対象物や、その先にあるモノの凹凸感を強調することで視認性そのものをサポートいたします。

●色彩を抑えスッキリ。

●輪郭と臨場感をクッキリ。
ラスター オレンジ
天候の急変にも暗さを感じさせない鮮明な視界を確保。明るさとコントラスト性能の絶妙なバランスが、動きのある場面でも高精度な立体感を実現します。

●心地よい明るさに視認。

●高精度な立体感を実現。
MO’EYE
もっと見える。
モアイ パープル
優雅なな印象をもつパープルを基調とした透明レンズに近い視界が、集中力を保ちます。オフィスワークや夜間の運転など日常生活に溢れる“雑光”をやわらげ、長時間の目への負担を軽減します。

●シャープな視界で快適。

●オフィスワークをも楽々。
モアイ グレー
見た色誤差の少ないグレーを基調とした透明レンズに近い視界が、オフィスワークや夜間の運転など日常生活に溢れる“雑光”をやわらげ、長時間の目への負担を軽減します。

●ナチュラルな視界が快適。

●オフィスワークをも楽々。
モアイ ブラウン
コントラスト性能をもつブラウンを基調にした透明レンズに近い見え方が、オフィスワークや夜間の運転など日常生活に溢れる“雑光”をやわらげ、優しい色合いで長時間の目への負担を軽減します。

●柔らかい見え方で楽々。

●パソコン画面をもっと快適に。
BRIGHT
明るく鮮明に見えます。
イーズ グリーン
薄暮どきの薄暗い夕方でも明るさをキープできる色合いと眩しさを抑える機能とのバランスは、サングラスレンズのイメージを一変させます。

●眩しさを最大限抑える

●驚くほど明るくスッキリ
ビスタ イエロー
イエローにグリーンをブレンドした視界は明るさを補いながらも光をソフトに整え、対象物の動きを捉えます。

●眩しさを緩和する

●明るく鮮やかな視界に
LIMITED
限定品。
イーズ グレー
雑光®を抑えながらも、表情を隠さない温和さを演出。
秋冬の景色に心地よいやわらかさをもたらし、視界まで穏やかにしてくれます。

●秋冬限定のイーズグレー

●目元まで優しく整う
イーズブルー
夏季節限定のカラー「イーズブルー」。空も海も、青く美しく。
気分を落ち着かせながらも、鮮やかで心地よい視界を実現。
日常の街並みを奥行きのある爽快な景色にシフトします。

●心地良い青で、鮮明に。

●気分を落ち着かせる季節限定カラーの偏光レンズ
エベレスト オレンジ
世界一過酷な場所で耐えうる品質と目を守る性能すべてを凝縮させたスペシャルレンズカラー。可視光線域では直接光を安全な視界確保レベルまで抑え、雪面からの反射光を見事にカットします。さらに8600m級という特異希な高所を想定し、目に見えない紫外線、ブルーライトはもちろん、赤外線をもカット。つまり、目に有害とされる光を可能な限りカットし、挑戦者の目への負担を最大限軽減できるレンズ、それがエベレストオレンジです。

●本レンズカラーは標高6000m以上の極地で目を守ることを優先しているため、信号識別不可・昼夜共運転不適合となります。

●世界の頂点を目指す挑戦者へ
取り扱い店舗:
眼鏡をかけている方のスポーツどきの眼鏡を真剣に考え、競技や年齢等に合ったスポーツメガネ等のご提案を行っています。特にハイカーブにおけるデザインの度数設定は最先端の技術を取り入れ、体験コーナーを設けて見え方の確認を行っています。
メガネのアマガンセンター店は、西は神戸市/芦屋市/西宮市と東は大阪市、北は伊丹市/川西市/宝塚市/三田市の間に位置する尼崎市で、1956年に眼鏡専門店として開業いたしました。
眼鏡専門店として最先端の技術をを取り揃えて「快適なメガネ」をご提案いたします
眼鏡専門店メガネのアマガン センター店の取り組み!
●読売新聞朝刊に当店の取り組みの取材を受け掲載されました・・・こちらへ
●毎日新聞朝刊に当店の取り組みの取材を受け掲載されました・・・こちらへ
●毎日新聞夕刊に当店の取り組みの取材を受け掲載されました・・・こちらへ
●日本眼科紀要会(日本の眼科学雑誌)への寄稿協力依頼を受けました・・・こちらへ
●週刊ゴルフダイジェストの取材を受けました1⃣・・・こちらへ
●週刊ゴルフダイジェストの取材を受けました2⃣・・・こちらへ
[最終更新日] 2026年06月03日 /[公開日] 2025年12月27日
カテゴリー:メガネ一覧,眼鏡屋,メガネ&サングラスと目について




















